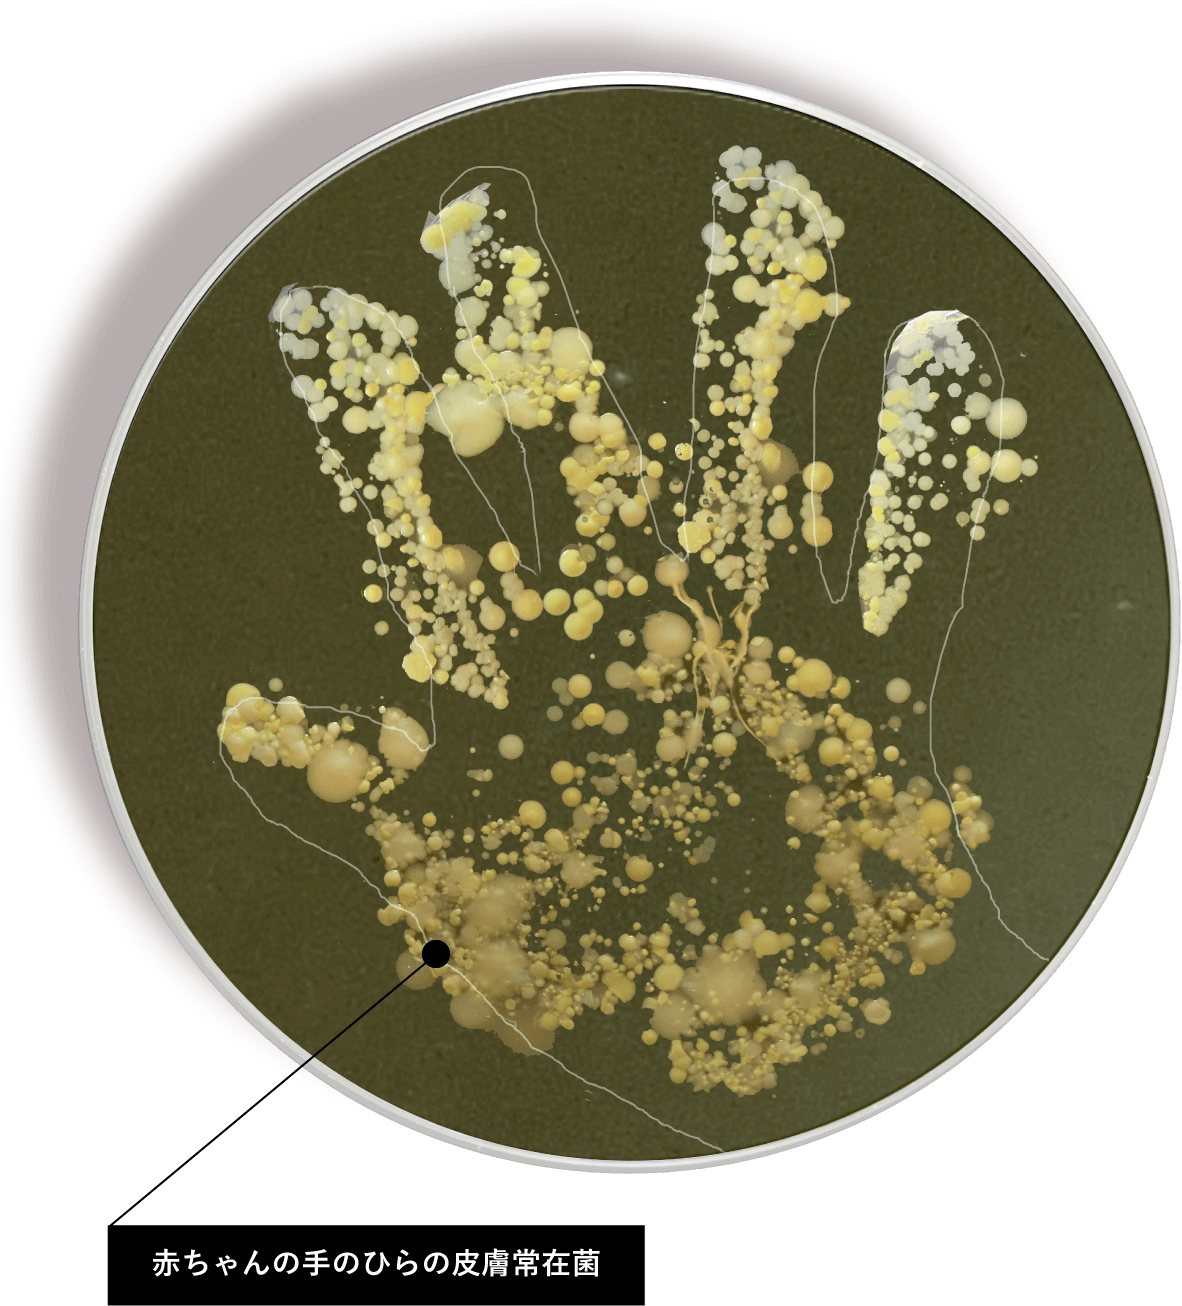
赤ちゃんの手のひらの皮膚常在菌

悪玉菌(黄色ブドウ球菌など)
肌に悪影響を及ぼす菌で、皮膚にいるだけでは特に問題はありませんが、傷口に付着すると炎症を招き、肌トラブルを起こす原因を作ります。
アトピーの方には多い菌とも言われています。
人間ひとりの表皮には
どのくらいの常在菌がいると思いますか?
乳酸菌・腸内環境研究を10年以上行なってきたエルピダは、腸内と同じように表皮にも常に常在菌がいて肌健康に大きく関係していることが分かりました。
ELPIDAがたどりついた「究極のエイジングケアシステム」それは・・・
人間ひとりの表皮には
約1兆個の常在菌がいます。
細菌というとあまり良いイメージではありませんが、私たちの表皮には
「善玉菌」「悪玉菌」「日和見菌」と大きく分けて3種類の常在菌が存在します。
そのなかで「善玉菌」=「美肌菌」が美しい肌への鍵を握っているのです。
エルピダはあなたが持っている美肌菌で
5年後、10年後も未来のあなたの肌を守ります。
あなたから採取した美肌菌が天然皮脂膜を産生し、肌本来の保湿力を高め紫外線や有害菌からお肌を守ります。
美しさの根源。それはあなた自身の肌にあります。

エルピダオンラインストアはこちら
あなたの美肌菌がはいったあなただけのオーダーメイドスキンケア商品はこちらからご注文いただけます。
What is Skin flora
美肌菌とは、正式には『表皮ブドウ球菌』という名称で美しい肌の人にはたくさん存在しています。逆に肌の状態が悪い人には『黄色ブドウ球菌』と呼ばれる悪い菌がたくさん皮膚に存在しています。
美肌菌は、皆さんの肌の上にある汗や皮脂(油分)を食べて保湿成分を作り弱酸性に保ってくれます。
この美肌菌が少ないと肌のバリア機能が低下するため、保湿力がなくなりカサついたり、肌の状態としてはよくないアルカリ性へと傾きます。
この状態では紫外線や異物をバリアすることが出来なくなりシミ・シワ等のトラブルを起こしてしまいます。

Origin of ELPIDA focusing on Skin flora
美肌菌は肌本来の機能を高めることがわかりました。
それでは美肌菌を増やすにはどのようにすればよいのでしょうか?
今までは特定の成分で美肌菌が増えやすい環境を整えるという考えが一般的でした。
しかし美肌菌の性質は人それぞれことなるので、特定の成分を含んでいるだけでは個人差があり、すべての人に対しては有効ではなかったのです。
それを解消するためエルピダは「自分自身の美肌菌を増やす」という最先端の研究に注目しました。



Skin flora research
人間ひとりにいる皮膚常在菌は約1兆個
長年の研究により腸内環境は「悪玉菌・善玉菌・日和見菌」の3種類の常在菌が存在していることが分かりました。
そして、皮膚にも菌が常在しており、そのバランスがお肌の状態に大きく関わっているのです。
肌本来がもっている美しさは、肌環境の変化で肌荒れや老化の原因を引き起こします。
善玉菌(表皮ブドウ球菌)=美肌菌
汗や皮脂を栄養として、保湿成分であるグリセリンを作り出し、肌のバリア機能を高める皮脂膜が、紫外線や乾燥から肌を守ります。
また、肌を弱酸性に保つことで悪玉菌を排除し、肌荒れ、ニキビ等の肌トラブルから肌を守り、気になる臭いを抑える働きもあります。

悪玉菌(黄色ブドウ球菌など)
肌に悪影響を及ぼす菌で、皮膚にいるだけでは特に問題はありませんが、傷口に付着すると炎症を招き、肌トラブルを起こす原因を作ります。
アトピーの方には多い菌とも言われています。


Demonstrate the effect of Skin Flora
美肌菌が黄色ブドウ球菌(悪玉菌)を抑制することができるのかを実験。
一方には培地に表皮ブドウ球菌を塗らず黄色ブドウ球菌をつけ、もう一方には培地に表皮ブドウ球菌(美肌菌)を塗り、黄色ブドウ球菌をつけました。

培養が安定する48時間後の状態では黄色ブドウ球菌が広がり全体が黄色になっています。この状態では、ニオイや肌トラブルの原因となります。

培養が安定する48時間後の状態では黄色ブドウ球菌は増殖せず、表皮ブドウ球菌『美肌菌』が黄色ブドウ球菌の増殖を抑制しているのが分かります。
Body odor caused by bacteria

「美肌菌」の働き
体臭等、嫌な臭いの主な原因は、汗や生活習慣、ホルモンバランスが原因で皮膚常在菌のバランスが崩れ、黄色ブドウ球菌(悪玉菌)が増殖する事により発生すると言われています。
実験から表皮ブドウ球菌「美肌菌」は黄色ブドウ球菌の増殖を抑制する働きがあると分かりました。
その為、「美肌菌」が体臭予防の手助けにもなると言う事が言えます。

オンリーワンの化粧品へと
美肌菌は1人ひとり特質が違うため自分自身の美肌菌を自分のお肌へ戻すことが美肌への近道だとエルピダは考えています。今の自分の美肌菌を採取しておけば、5年後、10年後でも自分の美肌菌をお肌へ戻すことができます。

History of skin flora research
いつまでも美しい「素肌美」をテーマに、エルピダがたどり着いたのは「美肌菌」でした。
「美肌菌」を増やす為に、大学の先生方や研究者の方々の協力を経て、独自培養方法を開発する事に成功。
自分の肌から採取した「美肌菌」を自分の肌に戻すという、今までにはなかった新しい手法の化粧品が生まれたのです。


POINT 1
東海大学と共同研究にて美肌菌
(表皮ブドウ球菌)を粉末化に成功。
その後、お客様の要望により液状化へ
POINT 2
自分の肌から採取された美肌菌を培養
し肌に戻す驚きのスキンケアの誕生
POINT 3
この中に数万個の美肌菌が-80℃で半永久に
厳重保管され要望があれば再培養され商品化

Flow of skin flora products
一度採取されたお客様の美肌菌はシリアルナンバーをつけ世界でただひとつの「美肌菌」として厳重に保管されます。

初回のお客様に美肌菌採取キットをお届けします。

洗顔後、オレンジ培地とガーゼで美肌菌を採取し、エルピダにご返送いただきます。

返送いただいた美肌菌を採取したガーゼを体液に近い液体に浸して、独自開発した培養技術で48時間培養します。

専門の研究員が選択工程を経て、最も優れた美肌菌を選びます。

選び抜かれた美肌菌を、あなたのお肌に戻すために必要な量である約10億個まで増やします。

あなただけの美肌菌培養液が完成し、研究室で-80℃で冷凍保存され生涯保存いたします。

商品に関するご質問やご注文は、以下よりご連絡ください。